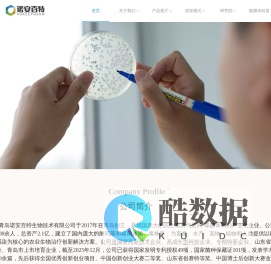
青岛诺安百特生物技术有限公司

最新
聊城家政,聊城保姆,聊城家政保姆,聊城家政公司,聊城家政服务公司,聊城保洁,聊城家庭保洁,聊城保洁公司,聊城保洁公司电话,聊城征婚,聊城征婚网,聊城月嫂培训中心,佳诚家政
佳诚家政是一家集聊城保洁,聊城家政,聊城搬家,聊城清洗,聊城月嫂,聊城保姆等服务于一体的家政保洁公司,主要服务于聊城家政,聊城保洁,聊城清洗,聊城搬家,聊城家政公司!咨询电话:15506461588